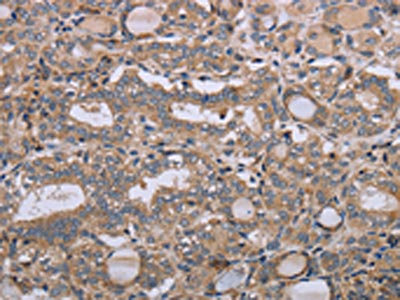

NAA25 Antibody
-
中文名稱:NAA25兔多克隆抗體
-
貨號(hào):CSB-PA150642
-
規(guī)格:¥1100
-
圖片:
-
其他:
產(chǎn)品詳情
-
Uniprot No.:
-
基因名:NAA25
-
別名:C12orf30 antibody; DKFZp667K2112 antibody; FLJ1308 antibody; MDM20 antibody; Mitochondrial distribution and morphology 20 antibody; Mitochondrial distribution and morphology protein 20 antibody; N(alpha)-acetyltransferase 25, NatB auxiliary subunit antibody; N-alpha-acetyltransferase 25, NatB auxiliary subunit antibody; N-terminal acetyltransferase B complex subunit MDM20 antibody; N-terminal acetyltransferase B complex subunit NAA25 antibody; Naa25 antibody; NAA25_HUMAN antibody; NAP1 antibody; NatB complex subunit MDM20 antibody; p120 antibody; TPR repeat-containing protein C12orf30 antibody
-
宿主:Rabbit
-
反應(yīng)種屬:Human
-
免疫原:Synthetic peptide of Human NAA25
-
免疫原種屬:Homo sapiens (Human)
-
標(biāo)記方式:Non-conjugated
-
抗體亞型:IgG
-
純化方式:Antigen affinity purification
-
濃度:It differs from different batches. Please contact us to confirm it.
-
保存緩沖液:-20°C, pH7.4 PBS, 0.05% NaN3, 40% Glycerol
-
產(chǎn)品提供形式:Liquid
-
應(yīng)用范圍:ELISA,IHC
-
推薦稀釋比:
Application Recommended Dilution ELISA 1:2000-1:5000 IHC 1:50-1:200 -
Protocols:
-
儲(chǔ)存條件:Upon receipt, store at -20°C or -80°C. Avoid repeated freeze.
-
貨期:Basically, we can dispatch the products out in 1-3 working days after receiving your orders. Delivery time maybe differs from different purchasing way or location, please kindly consult your local distributors for specific delivery time.
-
用途:For Research Use Only. Not for use in diagnostic or therapeutic procedures.
相關(guān)產(chǎn)品
靶點(diǎn)詳情
-
功能:Non-catalytic subunit of the NatB complex which catalyzes acetylation of the N-terminal methionine residues of peptides beginning with Met-Asp-Glu. May play a role in normal cell-cycle progression.
-
基因功能參考文獻(xiàn):
- Mdm20 acts as a novel regulator of Rictor, thereby controlling mTORC2 activity, and leading to the activation of PKCalphaS657 and FoxO1. PMID: 26600389
- The human NatB complex composed of Naa20 (NAT3) and Naa25 (MDM20) N-terminally acetylates Met-Glu-, Met-Asp-, Met-Asn- and Met-Gln- N-termini, and is important for the structure and function of actomyosin fibers and for proper cellular migration. PMID: 22814378
- The C120rf30 gene maps into a region of extensive linkage disequilibrium including several genes that represent functional candidates of type 1 diabetes-susceptibility. PMID: 20089178
- Human N-acetyltransferase complexe NatB consists of human N-acetyltransferase 3 and human MDM20. The hMDM20 knockdown decreased the fraction of cells in G(0)/G(1)-phase and increased the fraction of cells in the sub-G(0)/G(1)-phase. PMID: 18570629
- There are associations between juvenile idiopathic arthritis and variants in the TNFAIP3, STAT4, and C12orf30 regions that have previously shown associations with other autoimmune diseases, including rheumatoid arthritis and systemic lupus erythematosus. PMID: 19565500
- hMdm20 (C12orf30) is an auxiliary subunit of the human NatB N-terminal acetyltransferase complex while hNat3 (NAT5) is the catalytic subunit. This ribosome associated complex acetylates nascent Met-Asp/Glu- polypeptides. PMID: 18570629
顯示更多
收起更多
-
亞細(xì)胞定位:Cytoplasm.
-
蛋白家族:MDM20/NAA25 family
-
數(shù)據(jù)庫(kù)鏈接:
Most popular with customers
-
-
YWHAB Recombinant Monoclonal Antibody
Applications: ELISA, WB, IHC, IF, FC
Species Reactivity: Human, Mouse, Rat
-
Phospho-YAP1 (S127) Recombinant Monoclonal Antibody
Applications: ELISA, WB, IHC
Species Reactivity: Human
-
-
-
-
-